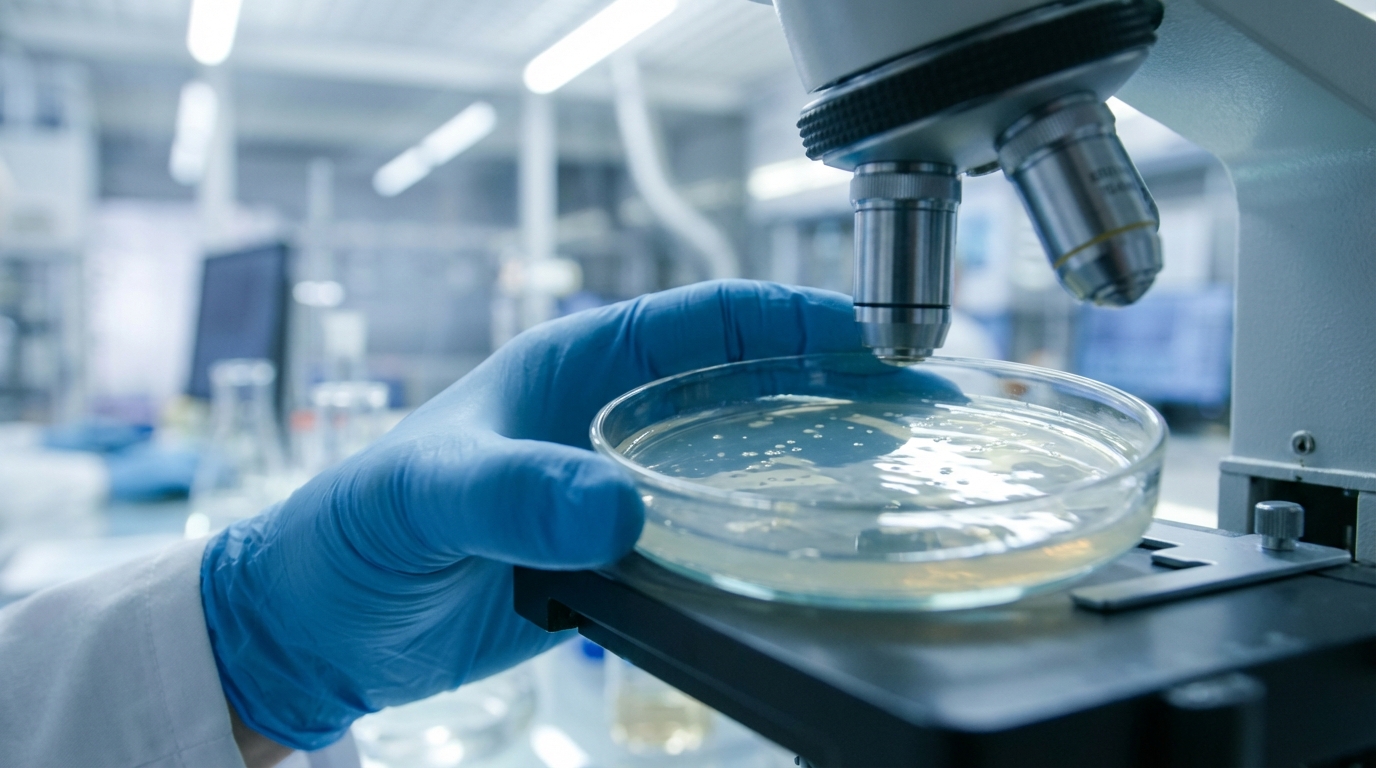
Revolutionary Cancer Therapy Eliminates 92% of Cancer Cells While Preserving Healthy Tissue

People in their 60s and 70s who keep these old-school habits report higher happiness than tech-focused younger adults
Every Thursday morning, the same small group gathers around a scratched wooden table in a local café in Lyon. No laptops, no AirPods, just cups of coffee leavin...